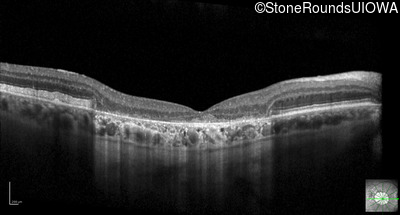
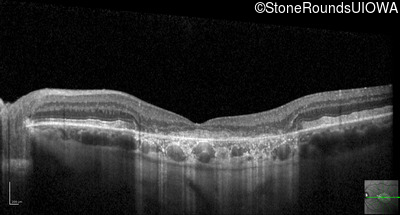

SR2904
Best Disease (IIB)
Male
Male
SR2904
Student Mode
1Best Disease (IIB)
2Male
Male
History
This 68 year old man experienced a gradual decline in his visual acuity following his cataract surgery 3 years ago.
| Age at visit: 31 years |
| OD | OS | ||
|---|---|---|---|
| Age at visit: 34 years |
| OD | OS | ||
|---|---|---|---|
Diagnosis & molecular findings
| Disease | Gene | Allele 1 variant(s) | Allele 2 variant(s) | Inheritance mode |
|---|---|---|---|---|
| Best Disease | BEST1 | Ala243Thr GCG>ACG | AD |